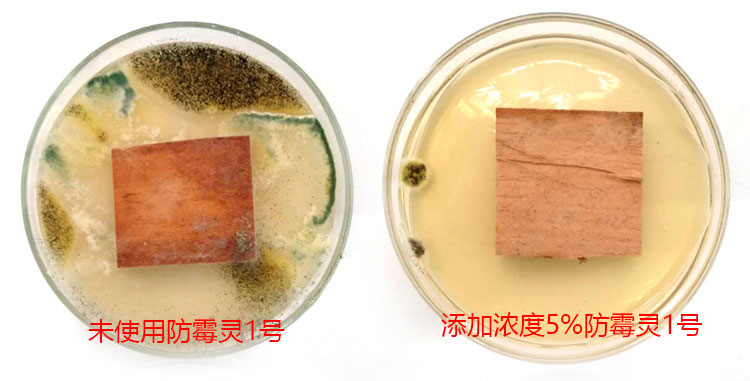
13599680322_42118989.jpg

菜板防霉剂(KS178)由多种防霉剂、抗菌剂、抗藻剂复合而成,主要针对实木这类含水量高、木质紧密,难以吸收的实木制品,如红铁木、银杏木等。
多组分复合乳化而成的防霉剂,能够快速渗透木材,被致密木纤维吸收,具有非常优异的防霉性能,能够抵抗高湿度材料的霉菌滋生。
菜板防霉剂具有非常广泛的抗菌谱,对霉菌和藻类、常见细菌都具明显抑制效果(见MIC参数表);

经处理过的菜板,具有很好的防霉能力,防霉等级0级,抗藻等级为0级,常见细菌抗菌率大于99%,可保护制品1年以上不受霉菌、藻类物质侵扰,延长使用寿命;
菜板防霉剂所使用抗菌剂通过Reach、Rohs、DMF FREE、CP65等相关环保认证,可以直接使用在与食品接触的物品上,详细的测试报告请于工作人员联系。
使用方法
将药剂按照1:20比例稀释,搅拌均匀,木制品浸泡即可。